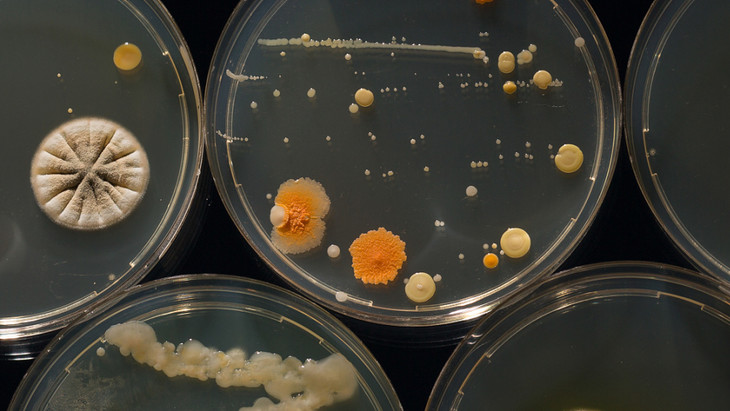

美容变毁容,别再这样做啦!
2021年07月19日

不要在把各种稀奇古怪的食物敷在脸上啦!

在一些朋友的知识误区中,能吃的东西就能抹脸上,纯天然就是安全的,完全没问题。

蜂蜜配柠檬,把蜂蜜加热后跟柠檬汁混合调匀,再均匀涂在脸上,等20分钟后洗净。

黄瓜配蛋清,黄瓜榨汁混合蛋清,再抹在脸上,据说用后皮肤很紧致。

以上配方一眼看去是哪家甜品配料单呢?

其实食物里的成分多是大分子,光抹脸上皮肤没法吸收,还容易让脸部皮肤成为细菌培养皿
有位宁波大姐现身说法,她用自制面膜后脸被灼伤了,皮肤又红又肿。

图源于 | 中国新闻网
与其费劲心思的‘研究’自制面膜,不如挑选一款安全天然的成品面膜

润耳金典黑面膜,真实添加银耳提取物(TREMELLA FUCIFORMIS),满满银耳多糖。


其小分子成分直接渗透到肌底层,深入补水、改善暗沉、亮泽肤色。

布采用了优质蚕丝膜布,厚度仅0.1mm、重量仅1.1g,质感亲肤又透气。

所以各位姐妹不要在发挥自己的想象力创造各种面膜啦,润耳金典黑她不香嘛!
50阅读
9赞
裕德源通江银耳润耳面膜旗舰店
